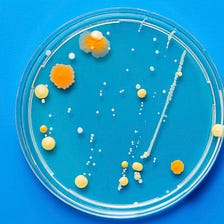

does sensodyne work reddit
Professional studies have actually revealed that level of sensitivity tooth paste containing potassium nitrate such as Sensodyne. By clicking the links above you will be taken to an external website that is independently operated and not managed by GSK.

My Girlfriend Thinks Highly Of Me R Funny
A few points to clarify everything.

. If your try sensodyne and it does not help you after 2. It does need to be built up over time and reapplied twice a day to remain effective. At the first brush it starts to form a protective barrier that quickly blocks.
There is nothing special about sensodyne that you cant find in. How long does it take for Sensodyne toothpaste to work. It works in 60 seconds to.
Sensodyne depending on which exact version you get either has an added chemical. At the internet marketing department here at CCP Web Design we looked at how Sensodyne typically compares with a leading sensitivity competitor Aquafresh sensitive. Sensodyne Rapid Relief uses an active ingredient called stannous fluoride to quickly build a layer over exposed dentin.
Normal teeth dont have this problem because it has enamel on it but enamel can break down for various reasons ie acid or wear of teeth. Best overall remineralizing toothpaste. Stannous fluoride toothpaste works by creating a barrier over areas of exposed dentin the soft inner part of the tooth to protect teeth from sensitivity triggers.
Graduating dentist here so everything is freshhh. My dentist was really upset when he found out that I have been using Sensodyne toothpaste as my regular toothpaste for a year now. Sensodyne works by blocking those tubes in the.
Best anti-cavity remineralizing toothpaste. Most toothpastes only use sodium fluoride to protect your enamel. Although once you have sensitive teeth it cannot be reversed switching to a daily sensitivity toothpaste like Sensodyne can protect against the symptoms of sensitivity when used twice a.
Sensodyne contains clinically proven ingredients for sensitivity relief while the. Tooth sensitivity occurs when. The potassium nitrate is thought to block open pores in the enamel protecting exposed nerves.
Im currently using Pronamel by Sensodyne apparently this is meant to target acid wear. Scorinth 6 yr. The scientists at Sensodyne a name synonymous with sensitive teeth have a toothpaste and mouthwash designed to help those sufferers.
The purpose of toothpaste is. In a December 2016 post on Reddits QA section rIamA a technician claiming to work in a toothpaste factory repeated the theory. Sensodyne is owned by GlaxoSmithKline and is marketed under the name Shumitect in Japan.
NovaMin didnt make it into US. Sensodyne and Pronamel are both daily toothpastes that offer cavity protection fresh taste and sensitivity relief. Sensodyne can be effective in reducing sensitivity in teeth due to gum recession.
My dentist says Sensodyne should not be used for more. It will not help decayed or broken teeth. Rapid Relief provides clinically proven rapid relief for sensitive teeth.
My dentist recommended me this toothpaste at the end of my last visit. What most people actually have is a poor diet andor poor dental habits that are learned or not learned from their parents. Best remineralizing toothpaste for sensitive teeth.
GSK assumes no responsibility for the content on the. Sensodyne is a daily toothpaste specially formulated to relieve and protect against tooth sensitivity and is the No1 dentist recommended toothpaste brand for sensitive teeth. For the average person it doesnt matter what toothpaste you are using.

Eli5 What Does Sensitive Teeth Toothpaste Actually Do To Your Teeth Like How Does It Work R Explainlikeimfive

This Toothpaste Describes What Each Of Its Ingredient Is And Its Purpose R Mildlyinteresting

Toothpaste Reddit Post Long Lasting Chapped Lips

Dentists Of Reddit What Toothpaste Do You Really Recommend R Askreddit

The Surprising Reason You May Be Suffering From Chapped Lips Her Ie

Sensodyne Pronamel Gentle Whitening R Dentistry

Is Sensodyne Worth The Price Or Will Any Sensitivity Toothpaste Work South Charlotte Dentisrty

20 Teeth Whiteners That Work So Well It S Like Magic
Why Is The Internet Obsessed With This Cult Toothpaste By Ashwin Rodrigues Elemental
Dentists Of Reddit What Toothpaste Do You Really Recommend R Askreddit

There S A Right Order To Flossing And Brushing Dentists Say

30 People Who Have The Worst Luck

If Your Lips Are Chapped This Might Be The Surprising Culprit Hellogiggleshellogiggles

Til There S Only One Type Of Toothpaste That Actually Rebuilds Enamel And Damage To Teeth As Opposed To Creating The Environment For Teeth To Repair Themselves Using A Chemical Called Novamin That
Reddit Users Are Putting Toothpaste On Genitals As A Lube Replacement

Sensodyne Pronamel Strong And Bright Enamel Toothpaste For Sensitive Teeth Mint 3 Oz 2 10 Or Less Amazon With S S R Deals Us

Amazon Com Hello Activated Charcoal Toothpaste Fluoride Toothpaste With Activated Charcoal Teeth Whitening Toothpaste With Fresh Mint And Coconut Oil No Sls Vegan Gluten Free 3 Pack 4 Oz Tubes Everything Else

